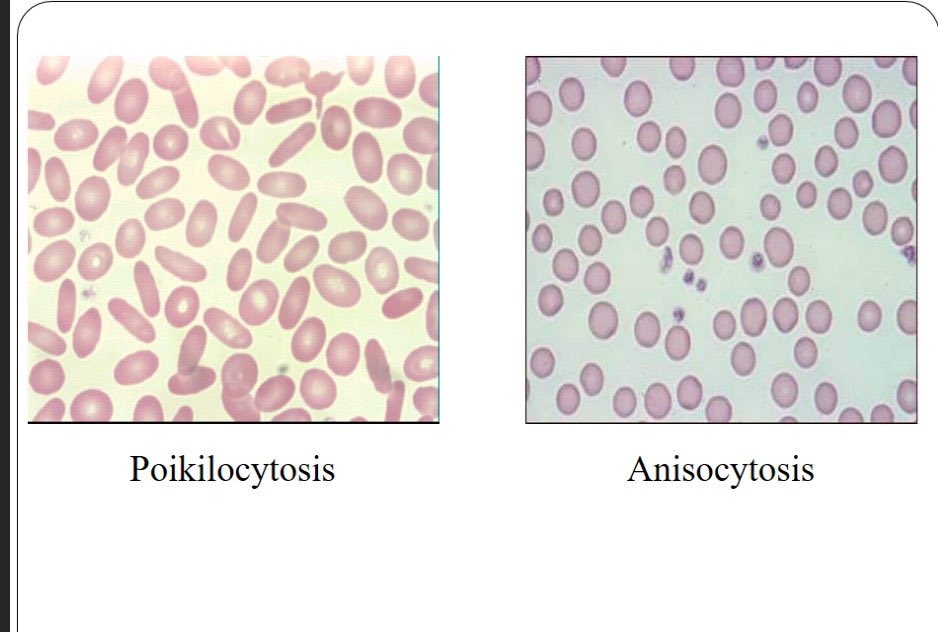
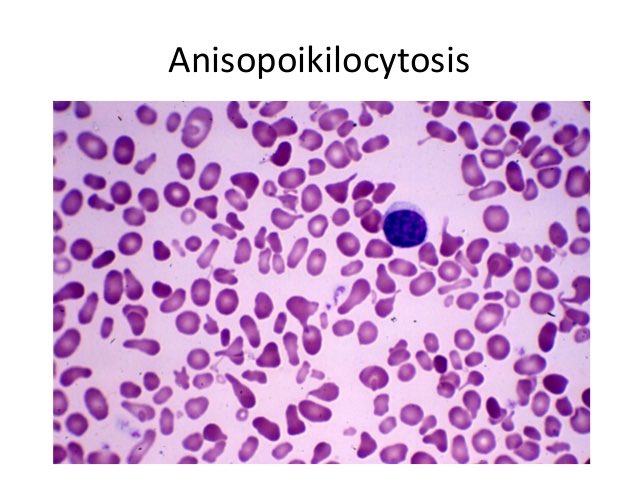
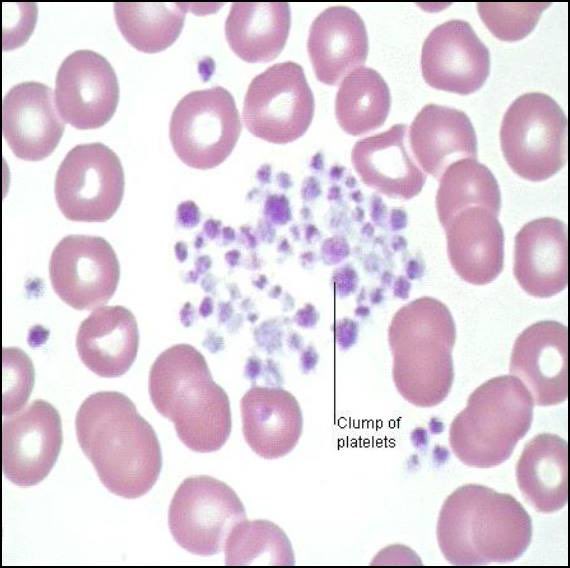

بتكلم عن :
📍استخدامه.
📍أنواعه وكيفية تحضيره.
📍العوامل الممكن تأثر جودة السمير.
📍وقراة الخلايا تحت المجهر.
📍استخدامه.
📍أنواعه وكيفية تحضيره.
📍العوامل الممكن تأثر جودة السمير.
📍وقراة الخلايا تحت المجهر.
⬛️ استخدامه:
هذا الفحص مهم في الكشف عن:
♦️أمراض الدم من خلال معرفة أشكال و أحجام خلايا الدم.
♦️وجود بعض الطفيليات في الدم.
⬛️ متى نستخدمه؟
🔸نشوف زياده او نقص في عدد خلايا الدم (نتائج CBC)
🔸نحتاج نحدد نوع الانيميا
🔸نعرف اذا لوكيميا acute or chronic
هذا الفحص مهم في الكشف عن:
♦️أمراض الدم من خلال معرفة أشكال و أحجام خلايا الدم.
♦️وجود بعض الطفيليات في الدم.
⬛️ متى نستخدمه؟
🔸نشوف زياده او نقص في عدد خلايا الدم (نتائج CBC)
🔸نحتاج نحدد نوع الانيميا
🔸نعرف اذا لوكيميا acute or chronic
⬛️ طيب كيف أحضر فلم الدم خفيفة⁉️
🔹نحتاج قطرة دم من أنبوب EDTA
🔹و شريحه من نوع (Frosted) ونسجل معلومات المريض
🔹و شريحة أخرى (spreader slide) لفرد قطرة الدم
🔹نحتاج قطرة دم من أنبوب EDTA
🔹و شريحه من نوع (Frosted) ونسجل معلومات المريض
🔹و شريحة أخرى (spreader slide) لفرد قطرة الدم
🔴 ولكن هناك عوامل تؤثر في جودة فلم الدم:
▪️حجم قطرة الدم.
اذا كانت كبيرة بيكون لسمير الدم غليظ (thick) وطويل أو اذا كانت صغيرة بيكون لسمير الدم رقيق(thin) وقصير.
▪️حجم قطرة الدم.
اذا كانت كبيرة بيكون لسمير الدم غليظ (thick) وطويل أو اذا كانت صغيرة بيكون لسمير الدم رقيق(thin) وقصير.
▪️زاوية الشريحة الثانية لفرد الدم.
إذا كانت فوق ٤٥ بيكون لسمير قصير أو إذا كانت اقل عن ٣٠ بيكون لسمير طويل.
▪️سرعة حركة الشريحة الثانية
إذا كانت سرعه كبيرة بيكون شكلها مثل شريط عمودي.
إذا كانت فوق ٤٥ بيكون لسمير قصير أو إذا كانت اقل عن ٣٠ بيكون لسمير طويل.
▪️سرعة حركة الشريحة الثانية
إذا كانت سرعه كبيرة بيكون شكلها مثل شريط عمودي.
⬛️ أما تحضير فلم الدم سميكة:
نضع قطرة دم على شريحة زجاجية آخرى وننشرها بشكل دائري باستخدام زاوية sperader slide
وبعد ذالك نصبغهااا بواسطة Giemsa Stain وبعد ما تنشف الشريحه، نشوفها تحت المجهر.
نضع قطرة دم على شريحة زجاجية آخرى وننشرها بشكل دائري باستخدام زاوية sperader slide
وبعد ذالك نصبغهااا بواسطة Giemsa Stain وبعد ما تنشف الشريحه، نشوفها تحت المجهر.
2️⃣
نشوف بعض انواع WBC الغير طبيعية :
ونقيمهااا +١، +٢ ….. +٤ مثل:
١- reactive lymphocyte
٢- toxic neutrophils
٣- hypersegmented neutrophils
وغيرها ….
نشوف بعض انواع WBC الغير طبيعية :
ونقيمهااا +١، +٢ ….. +٤ مثل:
١- reactive lymphocyte
٢- toxic neutrophils
٣- hypersegmented neutrophils
وغيرها ….
جاري تحميل الاقتراحات...